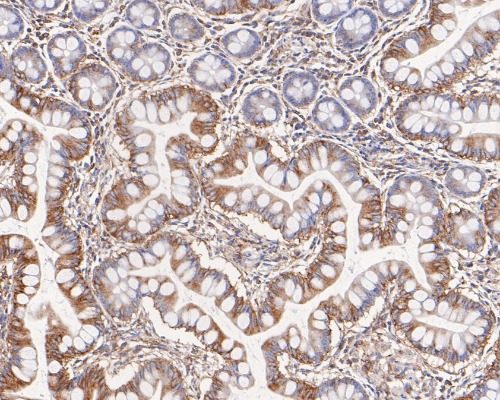

NSD3 Rabbit Monoclonal Antibody(ARA928)
CAT.NO. : ARA6765
RMB Please choose
RMB Please choose
Size:
Trail, Bulk size or Custom requests Please contact us
Background
The deduced 1,437 amino acid NSD3 protein contains two PWWP domains involved in protein-protein interactions, five PHD-type zinc finger motifs found in chromatin-associated proteins, a SAC (SET-associated cys-rich) domain, a SET domain and a C-terminal C5HCH domain. Two NSD3 variants have been identified. The short variant comprised of 645 amino acids, arises from alternative polyadenylation and exon splicing and contains a single PWWP domain. A longer NSD3 variant, which is only expressed in HeLa cells, is comprised of 1,388 amino acid residues. The human WHSC1L1 gene, which encodes the NSD3 protein, shares 68% and 55% identity with mouse Nsd1 and human WHSC1, respectively. Highest expression of NSD3 is observed in brain, heart and skeletal muscle tissues; lower levels of NSD3 expression are observed in the liver and lungs.
Application
|
Application |
Dilution Ratio |
|
WB |
1:200 - 1:10,000 |
|
FC |
1:50 - 1:100 |
|
IHC-P |
1:50 - 1:400 |
Overview
|
Antibody Type |
Recombinant Rabbit monoclonal Antibody |
|
Immunogen |
Synthetic peptide within Human NSD3 aa 1-50 / 1,437 |
|
Species Reactivity |
Human, Mouse, Rat |
|
Validated Applications |
WB, FC, IHC-P |
|
Molecular Weight |
Predicted band size: 162 kDa |
|
Positive Control |
HeLa cell lysate, MCF7 cell lysate, mouse brain tissue lysate, rat brain tissue lysate, rat eyeball tissue lysate, human small intestine tissue, human lymph nodes tissue, Hela |
|
Conjugation |
unconjugated |
|
Form |
Liquid |
|
Storage Buffer |
1*TBS (pH7.4), 0.05% BSA, 40% Glycerol. Preservative: 0.05% Sodium Azide |
|
Isotype |
IgG |
|
Purification Method |
Protein A affinity purified |
Data

Western blot analysis of NSD3 on different lysates with Rabbit anti-NSD3 antibody at 1/10,000 dilution.
Immunohistochemical analysis of paraffin-embedded human small intestine tissue using anti-NSD3 antibody.

Flow cytometric analysis of NSD3 was done on Hela cells. The cells were fixed, permeabilized and stained with the primary antibody (1/50) (red).
Storage
Store at +4℃ after thawing. Aliquot store at -20℃. Avoid repeated freeze / thaw cycles.
Research Use Only
For Research Use Only. Not for use in diagnostic procedures.
New Products
